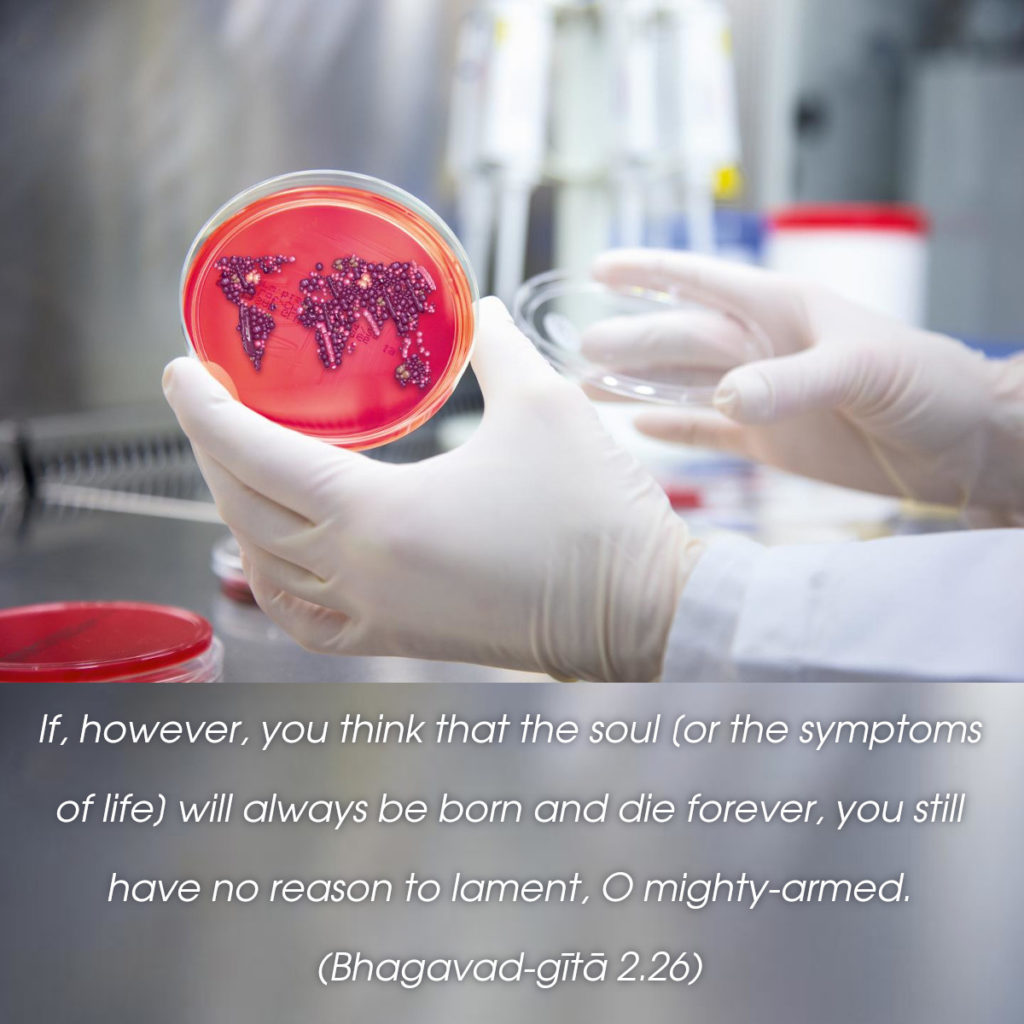
Bhagavad Gita: Chapter 2, Verse 26

अथ चैनं नित्यजातं नित्यं वा मन्यसे मृतम् |
तथापि त्वं महाबाहो नैवं शोचितुमर्हसि || 26||
atha chainaṁ nitya-jātaṁ nityaṁ vā manyase mṛitam
tathāpi tvaṁ mahā-bāho naivaṁ śhochitum arhasi
atha—if, however; cha—and; enam—this soul; nitya-jātam—taking constant birth; nityam—always; vā—or; manyase—you think; mṛitam—dead; tathā api—even then; tvam—you; mahā-bāho—mighty-armed one, Arjun; na—not; evam—like this; śhochitum—grieve; arhasi—befitting
Translation:
O mighty-armed Arjuna! Even if you think that Self is constantly born and dies, you should not grieve in this way.
Commentary:
In the previous verses, Krishna asked us not to worry about the indestructible spirit. A question may arise: Should one lament the death of (the destructible body of) our near and dear ones at all?
Mighty-armed: The Lord addresses Arjuna as ‘mighty-armed. Arjuna was endowed with great physical strength and energy. But it was of no avail to him in that perplexity situation. His physical strength could not help him in his mental confusion and sorrow. So the Lord suggests that he should acquire spiritual light and knowledge, besides physical strength and energy.
The Lord argues out the point from the lower level of ordinary human understanding, in order to comfort Arjuna and lift him up to the higher level of spiritual insight. Even if the Self of man is, constantly born and constantly dies, there is no cause for grief; for, whatever dies takes a fresh birth again. The ordinary man whose insight does not go deep enough to comprehend the eternal Atma, sees that the body dies. When it dies, it should have again a birth. It is the process of endless repetition. So, why grieve when the bodies are destroyed? The Lord knows that mere theoretical affirmation of the immortality of Atma may not be immediately understood by his disciple. So he gives a practical reason which the common man can easily understand.
But the practical arguments are mere assumptions of the limited intellect only. Even if it is taken that Atma, like the body, is subject to birth and death and rebirth, there is no need to grieve for the destruction of the body. It follows that it is utter madness to grieve for Atma which is real, deathless, and eternal.